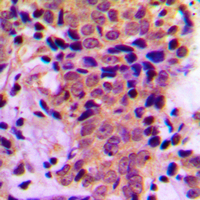
2 - Anti-ATF4 (pS245) Antibody AP59971

Anti-ATF4 (pS245) Antibody
Rabbit polyclonal antibody to ATF4 (pS245)
- 产品详情
- 实验流程
- 背景知识
Application
| WB, IHC |
|---|---|
| Primary Accession | P18848 |
| Other Accession | Q06507 |
| Reactivity | Human, Mouse, Rat |
| Host | Rabbit |
| Clonality | Polyclonal |
| Calculated MW | 38590 Da |
| Gene ID | 468 |
|---|---|
| Other Names | CREB2; TXREB; Cyclic AMP-dependent transcription factor ATF-4; cAMP-dependent transcription factor ATF-4; Activating transcription factor 4; Cyclic AMP-responsive element-binding protein 2; CREB-2; cAMP-responsive element-binding protein 2; DNA-binding protein TAXREB67; Tax-responsive enhancer element-binding protein 67; TaxREB67 |
| Target/Specificity | KLH-conjugated synthetic peptide encompassing a sequence within the center region of human ATF4 (pS245). The exact sequence is proprietary. |
| Dilution | WB~~WB (1/500 - 1/1000), IHC (1/100 - 1/200) IHC~~WB (1/500 - 1/1000), IHC (1/100 - 1/200) |
| Format | Liquid in 0.42% Potassium phosphate, 0.87% Sodium chloride, pH 7.3, 30% glycerol, and 0.09% (W/V) sodium azide. |
| Storage | Store at -20 °C.Stable for 12 months from date of receipt |
| Name | ATF4 {ECO:0000303|PubMed:2516827, ECO:0000312|HGNC:HGNC:786} |
|---|---|
| Function | Transcription factor that binds the cAMP response element (CRE) (consensus: 5'-GTGACGT[AC][AG]-3') and displays two biological functions, as regulator of metabolic and redox processes under normal cellular conditions, and as master transcription factor during integrated stress response (ISR) (PubMed:16682973, PubMed:17684156, PubMed:31023583, PubMed:31444471, PubMed:32132707). Binds to asymmetric CRE's as a heterodimer and to palindromic CRE's as a homodimer (By similarity). Core effector of the ISR, which is required for adaptation to various stress such as endoplasmic reticulum (ER) stress, amino acid starvation, mitochondrial stress or oxidative stress (PubMed:31023583, PubMed:32132707). During ISR, ATF4 translation is induced via an alternative ribosome translation re-initiation mechanism in response to EIF2S1/eIF-2-alpha phosphorylation, and stress-induced ATF4 acts as a master transcription factor of stress-responsive genes in order to promote cell recovery (PubMed:31023583, PubMed:32132706, PubMed:32132707). Promotes the transcription of genes linked to amino acid sufficiency and resistance to oxidative stress to protect cells against metabolic consequences of ER oxidation (By similarity). Activates the transcription of NLRP1, possibly in concert with other factors in response to ER stress (PubMed:26086088). Activates the transcription of asparagine synthetase (ASNS) in response to amino acid deprivation or ER stress (PubMed:11960987). However, when associated with DDIT3/CHOP, the transcriptional activation of the ASNS gene is inhibited in response to amino acid deprivation (PubMed:18940792). Together with DDIT3/CHOP, mediates programmed cell death by promoting the expression of genes involved in cellular amino acid metabolic processes, mRNA translation and the terminal unfolded protein response (terminal UPR), a cellular response that elicits programmed cell death when ER stress is prolonged and unresolved (By similarity). Activates the expression of COX7A2L/SCAF1 downstream of the EIF2AK3/PERK-mediated unfolded protein response, thereby promoting formation of respiratory chain supercomplexes and increasing mitochondrial oxidative phosphorylation (PubMed:31023583). Together with DDIT3/CHOP, activates the transcription of the IRS-regulator TRIB3 and promotes ER stress- induced neuronal cell death by regulating the expression of BBC3/PUMA in response to ER stress (PubMed:15775988). May cooperate with the UPR transcriptional regulator QRICH1 to regulate ER protein homeostasis which is critical for cell viability in response to ER stress (PubMed:33384352). In the absence of stress, ATF4 translation is at low levels and it is required for normal metabolic processes such as embryonic lens formation, fetal liver hematopoiesis, bone development and synaptic plasticity (By similarity). Acts as a regulator of osteoblast differentiation in response to phosphorylation by RPS6KA3/RSK2: phosphorylation in osteoblasts enhances transactivation activity and promotes expression of osteoblast-specific genes and post- transcriptionally regulates the synthesis of Type I collagen, the main constituent of the bone matrix (PubMed:15109498). Cooperates with FOXO1 in osteoblasts to regulate glucose homeostasis through suppression of beta-cell production and decrease in insulin production (By similarity). Activates transcription of SIRT4 (By similarity). Regulates the circadian expression of the core clock component PER2 and the serotonin transporter SLC6A4 (By similarity). Binds in a circadian time-dependent manner to the cAMP response elements (CRE) in the SLC6A4 and PER2 promoters and periodically activates the transcription of these genes (By similarity). Mainly acts as a transcriptional activator in cellular stress adaptation, but it can also act as a transcriptional repressor: acts as a regulator of synaptic plasticity by repressing transcription, thereby inhibiting induction and maintenance of long- term memory (By similarity). Regulates synaptic functions via interaction with DISC1 in neurons, which inhibits ATF4 transcription factor activity by disrupting ATF4 dimerization and DNA-binding (PubMed:31444471). |
| Cellular Location | Nucleus. Nucleus speckle. Cytoplasm {ECO:0000250|UniProtKB:Q9ES19}. Cell membrane {ECO:0000250|UniProtKB:Q9ES19}. Cytoplasm, cytoskeleton, microtubule organizing center, centrosome Note=Colocalizes with GABBR1 in hippocampal neuron dendritic membranes (By similarity). Colocalizes with NEK6 at the centrosome (PubMed:20873783). Recruited to nuclear speckles following interaction with EP300/p300 (PubMed:16219772). {ECO:0000250|UniProtKB:Q9ES19, ECO:0000269|PubMed:16219772, ECO:0000269|PubMed:20873783} |
Research Areas
For Research Use Only. Not For Use In Diagnostic Procedures.
Application Protocols
Provided below are standard protocols that you may find useful for product applications.
BACKGROUND
KLH-conjugated synthetic peptide encompassing a sequence within the center region of human ATF4 (pS245). The exact sequence is proprietary.
终于等到您。ABCEPTA(百远生物)抗体产品。
点击下方“我要评价 ”按钮提交您的反馈信息,您的反馈和评价是我们最宝贵的财富之一,
我们将在1-3个工作日内处理您的反馈信息。
如有疑问,联系:0512-88856768 tech-china@abcepta.com.
¥ 1,500.00
Cat# AP59971























 癌症的基本特征包括细胞增殖、血管生成、迁移、凋亡逃避机制和细胞永生等。找到癌症发生过程中这些通路的关键标记物和对应的抗体用于检测至关重要。
癌症的基本特征包括细胞增殖、血管生成、迁移、凋亡逃避机制和细胞永生等。找到癌症发生过程中这些通路的关键标记物和对应的抗体用于检测至关重要。 为您推荐一个泛素化位点预测神器——泛素化分析工具,可以为您的蛋白的泛素化位点作出预测和评分。
为您推荐一个泛素化位点预测神器——泛素化分析工具,可以为您的蛋白的泛素化位点作出预测和评分。 细胞自噬受体图形绘图工具为你的蛋白的细胞受体结合位点作出预测和评分,识别结合到自噬通路中的蛋白是非常重要的,便于让我们理解自噬在正常生理、病理过程中的作用,如发育、细胞分化、神经退化性疾病、压力条件下、感染和癌症。
细胞自噬受体图形绘图工具为你的蛋白的细胞受体结合位点作出预测和评分,识别结合到自噬通路中的蛋白是非常重要的,便于让我们理解自噬在正常生理、病理过程中的作用,如发育、细胞分化、神经退化性疾病、压力条件下、感染和癌症。